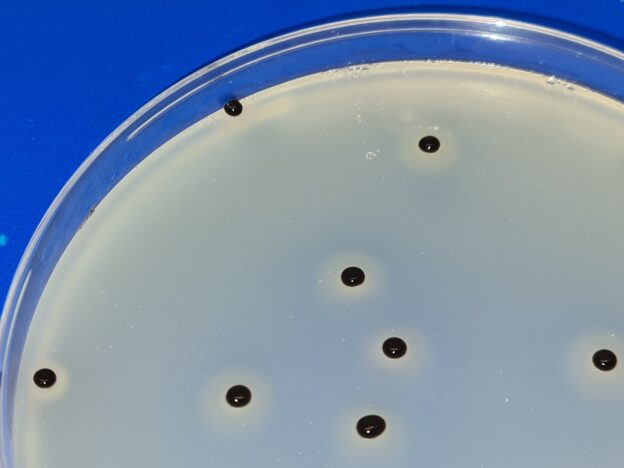

Staphylococus aureus: detección y recuento rápidos en alimentos, cosméticos, superficies, aire, agua…… Baird Parker cromogénico
Staphylococus aureus: detección
LAS MONOGRAFÍAS DE MICROKIT. Tema 1: ESTAFILOCOCO DORADO
1-El microorganismo y su interrelación con el ser humano
Staphylococcus aureus (abreviado S.aureus o St.aureus y popularmente conocido como estafilococos dorado) es un coco Gram positivo (se tiñe de azul-violeta en Gram al microscopio y no filamenta en Neogram directo en la colonia)
cuyas células coloniales se agrupan en forma de racimos cuando se miran al microscopio.
Se comporta como facultativa (aerobia o anaerobia a conveniencia).
La mayoría de sus cepas son coagulasa positivas, termonucleasa positivas, oxidasa negativas y catalasa positivas.
No tiene flagelos (es inmóvil) ni necesita esporas (su diminuta célula esférica ya es en si una forma de resistencia).
Se desarrolla bien en todos los medios de cultivo convencionales, fermenta lentamente carbohidratos, como el manitol, pero sin producir gas.
Produce pigmentos que varían de unas cepas a otras y de unos medios a otros, desde un color blanco hasta un amarillo intenso.
Aparte de otros muchos hábitats (se considera ubicuo), se encuentra como comensal en la piel y mucosas de cerca del 30% de personas (portadores asintomáticos)
junto con otros estafilococos no patógenos (S.epidermidis, S.hominis y otras muchas cepas que provocan el olor a sudor, normalmente más acentuado en los varones por tener mayor proporción de S.hominis y S.aureus).
Esta bacteria se localiza en el cuerpo humano en el interior de la nariz, pliegues (ingles, perineo, axilas…) y vagina.
Dado su ligero tamaño (0,5 a 1 μm de diámetro), todos ellos viven sin problema suspendidos en el aire (no “caen”), vía por donde se transmiten.
St.aureus puede producir una amplia gama de enfermedades, sobre todo en personas inmunodeprimidas,
que van desde infecciones de la piel y mucosas: foliculitis (infección en los orificios de los folículos pilosos, con lesiones dolorosas, rojizas y pequeñas), forunculosis (granos con pus amarillo), conjuntivitis…,
a otras enfermedades (celulitis, mastitis, abscesos profundos, osteomielitis…)
e incluso a enfermedades sistémicas mortales (sepsis, meningitis, endocarditis, neumonía…).
La Toxina-1 del síndrome de shock tóxico (TSST-1) es una toxina termoestable y resistente a proteólisis que actúa como un superantígeno.
Esta patología está asociada con la infección de una herida por S. aureus. Provoca un mortalidad elevada en ausencia de tratamiento.
Además, provocan toxiinfecciones alimentarias incluso cuando ya no están presentes en el alimento:
el calor destruye sus células, pero el 30% de cepas de S.aureus puede producir una enterotoxina muy termoresistente, en correlación con la termonucleasa,
estable incluso al calentar los alimentos más de 100 °C durante 30 minutos,
además es resistente a la hidrólisis por enzimas gástricas y pancreáticas).
De ahí que su ausencia no implique necesariamente que un alimento sea comestible, si ha estado presente en sus materias primas o antes del tratamiento térmico en el producto final).
Esta realidad se tiene en cuenta en alimentos, pero no en otras matrices que no se ingieren (aguas de baño y cosméticos). ¿Qué sucede en medicamentos?
La intoxicación provoca vómitos intensos, diarrea y cólicos que inician entre 2 y 6 horas después de la ingesta.
La resolución es rápida (menos de 24 h).
Es el mayor agente actual de infecciones nosocomiales (adquiridas por los pacientes en los propios hospitales),
debido a su resistencia a diversos antibióticos, incluidas las penicilinas (el 80% de S. aureus en la actualidad es resistente a la penicilina),
entre ellas Meticilina y Oxacilina, la primera de las cuales le ha dado a esta bacteria su nombre clínico de moda: MRSA o SARM (siglas de St.aureus Meticilin Resistente).
Las ß lactamasas son enzimas que inactivan a la penicilina, uno de los mecanismos de defensa de SARM.
Estas enzimas pueden inhibirse para así evitar que destruyan a las penicilinas susceptibles, lo cual se logra mediante la adición de ácido clavulánico junto con la penicilina.
Esta bacteria es uno de los mejores ejemplos de la guerra sin fin entre los microorganismos y el hombre con los diferentes antibióticos aplicados desde que se descubrieron.
2-Los tipos de productos donde la legislación exige su búsqueda o recuento, así como otros tipos de productos donde a nuestro criterio, sería recomendable analizarlos
Medicamentos
Cosméticos
Aguas de baño (en algunas CCAA)
Los siguientes alimentos:
caldos, cremas, carnes refrigeradas, congeladas o picadas (y derivados), jamón cocido, productos de la pesca, comidas preparadas con y sin tratamiento térmico…
…productos dietéticos, semiconservas, cuajo, vegetales congelados, galletas, gelatinas, productos lácteos y helados derivados de lácteos…
…horchata, levadura, ovoproductos, pastelería, bollería, confitería, repostería, aperitivos, turrones, mazapanes
A nuestro entender, debería buscarse además en todo alimento manipulado por personas
y en aguas de baño en todas las CCAA.
Del mismo modo, en todo alimento y medicamento oral deberían buscarse las cepas termonucleasa positivas.
3-Los métodos oficiales para su detección/recuento
Pharmacopea en medicamentos:
Mannitol Salt Agar o Vogel Johnson Agar (el Baird Parker Agar fue eliminado) y coagulasa
No existe método oficial en cosméticos,
aunque muchos laboratorios siguen la Normas Técnica ISO que invita al uso de Baird Parker Agar, lo cual genera numerosos resultados falsamente positivos y falsamente negativos, al ser un medio diseñado para eliminar una alta carga acompañante (alimentos) sin tener en cuenta las cepas estresadas/subletales de S.aureus
No existe método oficial en aguas de baño
y por extrapolación suele emplearse filtración de membrana sobre Baird Parker Agar (mismas salvedades que hemos indicado en cosméticos)
ISO 6888 en alimentos,
con Giolitti Cantoni para enriquecimiento y Baird Parker Agar para aislamiento y recuento. Coagulasa.
4-Los métodos alternativos que mejoran la rapidez de los resultados y la robustez del análisis
El caldo Manitol Salt Broth
permite un enriquecimiento más selectivo que el Giolitti-Cantoni Broth (y por supuesto que el TSB, agua de peptona, LPT Broth…) cuando la carga de microbiota acompañante es elevada y, en vez de recuento, se busca la ausencia de S.aureus.
Medios cromogénicos
El descubrimiento en la ultima década del siglo pasado de los agares cromogénicos permite una detección mucho más fiable (enzimática, en vez de la bioquímica que es propia de los medios de cultivo convencionales).
Por ejemplo el BPX19 Agar (Baird Parker cromogénico) detecta con mayor fiabilidad que el Baird Parker clásico, el rpf, el Vogel Johnson o el Manitol Salt Agar las cepas de estafilococos.
En dicho medio, S.aureus crece con pequeñas colonias azul oscuro o violeta (a veces con viraje hacia el púrpura), mientras las demás cepas de estafilococos crecen con pequeñas colonias verdes.
Pueden crecer especies de Bacillus con tonos azulados, pero lo hacen con colonias muy grandes, nada similares a las de estafilococos.
Si añadimos yema de huevo (sin telutito) a este medio, veremos además la actividad lecitinasa de cada colonia (por su halo de lisis).
La coagulasa
está presente en la mayoría de las cepas de S. aureus, y constituye una prueba muy sensible y específica para esta bacteria.
La coagulasa puede unirse al fibrinógeno y convertirlo en fibrina insoluble, la cual tiende a formar depósitos donde los estafilococos pueden agregarse (semejando a las plaquetas) y formar grupos.
Los látex de coagulasa permiten detectarla en escasos segundos a partir de las colonias sospechosas.
Los medios que incluyen detector de coagulasa (rpf) demuestran en intercomparación no interpretarse bien por parte de sus usuarios (cerca del 50% de falsos positivos y del 50% de falsos negativos).
Catalasa
En la prueba para detectar la catalasa, al aplicar peróxido de hidrógeno a la colonia, en la mayoría de cepas de S.aureus se nota la aparición de pequeñas burbujas de oxígeno, pero hay algunas cepas catalasa negativas, por lo que es una prueba menos específica que la coagulasa.
Mannitol
En la prueba de fermentación de manitol, el cambio de color de naranja a amarillo indica el empleo del manitol (Agar Mannitol Hipersalino). Pero muchas cepas de S.aureus no fermentan el manitol, por lo que dan falso negativo en este medio; y muchas de otras cepas sí lo fermentan, por lo que dan falso positivo en este medio.
Termonucleasa
Las cepas que generan enterotoxina termoresistente se detectan gracias al crecimiento con halo en el agar DNA-asa, que se convierte en agar termonucleasa al añadirle azul de toluidina, para mejor visualización de los halos rosas de lisis que provocan las colonias en el ADN presente en el medio cuando se añade HCl.
La detección concreta de las enterotoxinas en las cepas de S. aureus tiene un costo elevado. Por esta razón generalmente no se realiza y se asume que las cepas productoras de coagulasa y termonucleasa son enterotoxigénicas.
5-Cómo vemos el futuro en la detección de esta cepa
Dada la facilidad de intercambio genético entre células de diferentes especies de estafilococos, en vez de S.aureus proponemos buscar estafilococos patógenos (coagulasa positivos, con motivo de la facilidad de uso de látex de respuesta prácticamente inmediata).
Esto acabaría con la incongruencia de la Norma ISO 6888, que dice que S.aureus forma colonias negras con borde blanco y halo de lisis en BairdParker,
pero a veces las colonias crecen sin halo,
a veces no son negras…
Y permitiría el uso con mayor fiabilidad de medios enzimáticos (cromogénicos) como BPX19 Agar, haciendo la coagulasa a cualquier colonia diminuta, fuese azul-violácea, fuese azul-turquesa o verdosa.
Aunque la prueba de la DNA-asa no es inmediata, se debería añadir a la de la coagulasa en alimentos y medicamentos orales,
para demostrar la ausencia de enterotoxina estafilocócica que podría haber sido dejada como contaminante por células de St.aureus que estuvieron presentes en alguna de las materias primas y ya no lo están.
Si desea esta monografía completa en pdf, con las fotos que aqui no aparecen, solicítela en consultastecnicas@microkit.es
https://www.microkit.es/fichas/BAIRD-PARKER-AGAR-polvo.pdf
https://www.microkit.es/fichas/baird-parker-bpx19-cromogenic-agar-polvo.pdf
https://www.microkit.es/fichas/STAPH-COAGULASA-M-IDENT-LATEX.pdf